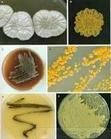
直串馬杜拉放線菌

簡介
在氣絲上形成直的短孢子鏈,有的彎曲。孢子球形、橢圓形,表面多褶皺(側面觀察有不規則疣刺)。全細胞水解液含內消旋二氨基庚二酸、半乳糖和馬杜拉糖。高氏合成1號瓊脂:氣絲白色或淺乳脂色。基絲褐粉至粉褐、紫褐、暗褐色。在所用培養基內均無可溶色素。林氏甘油硝酸鹽瓊脂:氣絲白色、微乳脂色或無。基絲無色。蔗糖硝酸鹽瓊脂:氣絲白色,少。基絲無色或微粉色。克氏合成1號瓊脂:不生長。甘油天冬素瓊脂:氣絲豐茂,白色,有時少。基絲無色至褐黃色。澱粉銨鹽瓊脂:無氣絲。基絲微黃、微粉色。燕麥瓊脂:氣絲白色、淺乳脂色。基絲豐茂,暗黃至褐粉色。高氏有機2號瓊脂:氣絲無或少,乳脂色。基絲豐茂,無色、淺黃或粉褐色。不產生類黑色素。碳源利用因株各異,INA308利用木糖良好,在葡萄糖、蔗糖、棉子糖上生長弱;INA18322隻在葡萄糖上生長好,在阿拉伯糖、木糖、蔗糖、鼠李糖、棉子糖上生長弱;INA707不利用ISP9種碳源。產生抗生素308,抑制革蘭氏陽性細菌、啤酒酵母。 直串馬杜拉放線菌
直串馬杜拉放線菌放線菌
| 放線菌因菌落呈放線狀而的得名。它是一個原核生物類群,在自然界中分布很廣,主要以孢子繁殖,其次是斷裂生殖。放線菌在自然界分布廣泛,主要以孢子或菌絲狀態存在於土壤、空氣和水中,尤其是含水量低、有機物豐富、呈中性或微鹼性的土壤中數量最多。放線菌只是形態上的分類,不是生物學分類的一個名詞。有些細菌和真菌都可以劃歸到放線菌。土壤特有的泥腥味,主要是放線菌的代謝產物所致。 |
盤點真菌微生物系列(十)
| 真菌(fungus;eumycetes)是具有真核和細胞壁的異養生物。種屬很多,已報導的屬達1萬以上,種超過10萬個。其營養體除少數低等類型為單細胞外,大多是由纖細管狀菌絲構成的菌絲體。 |
